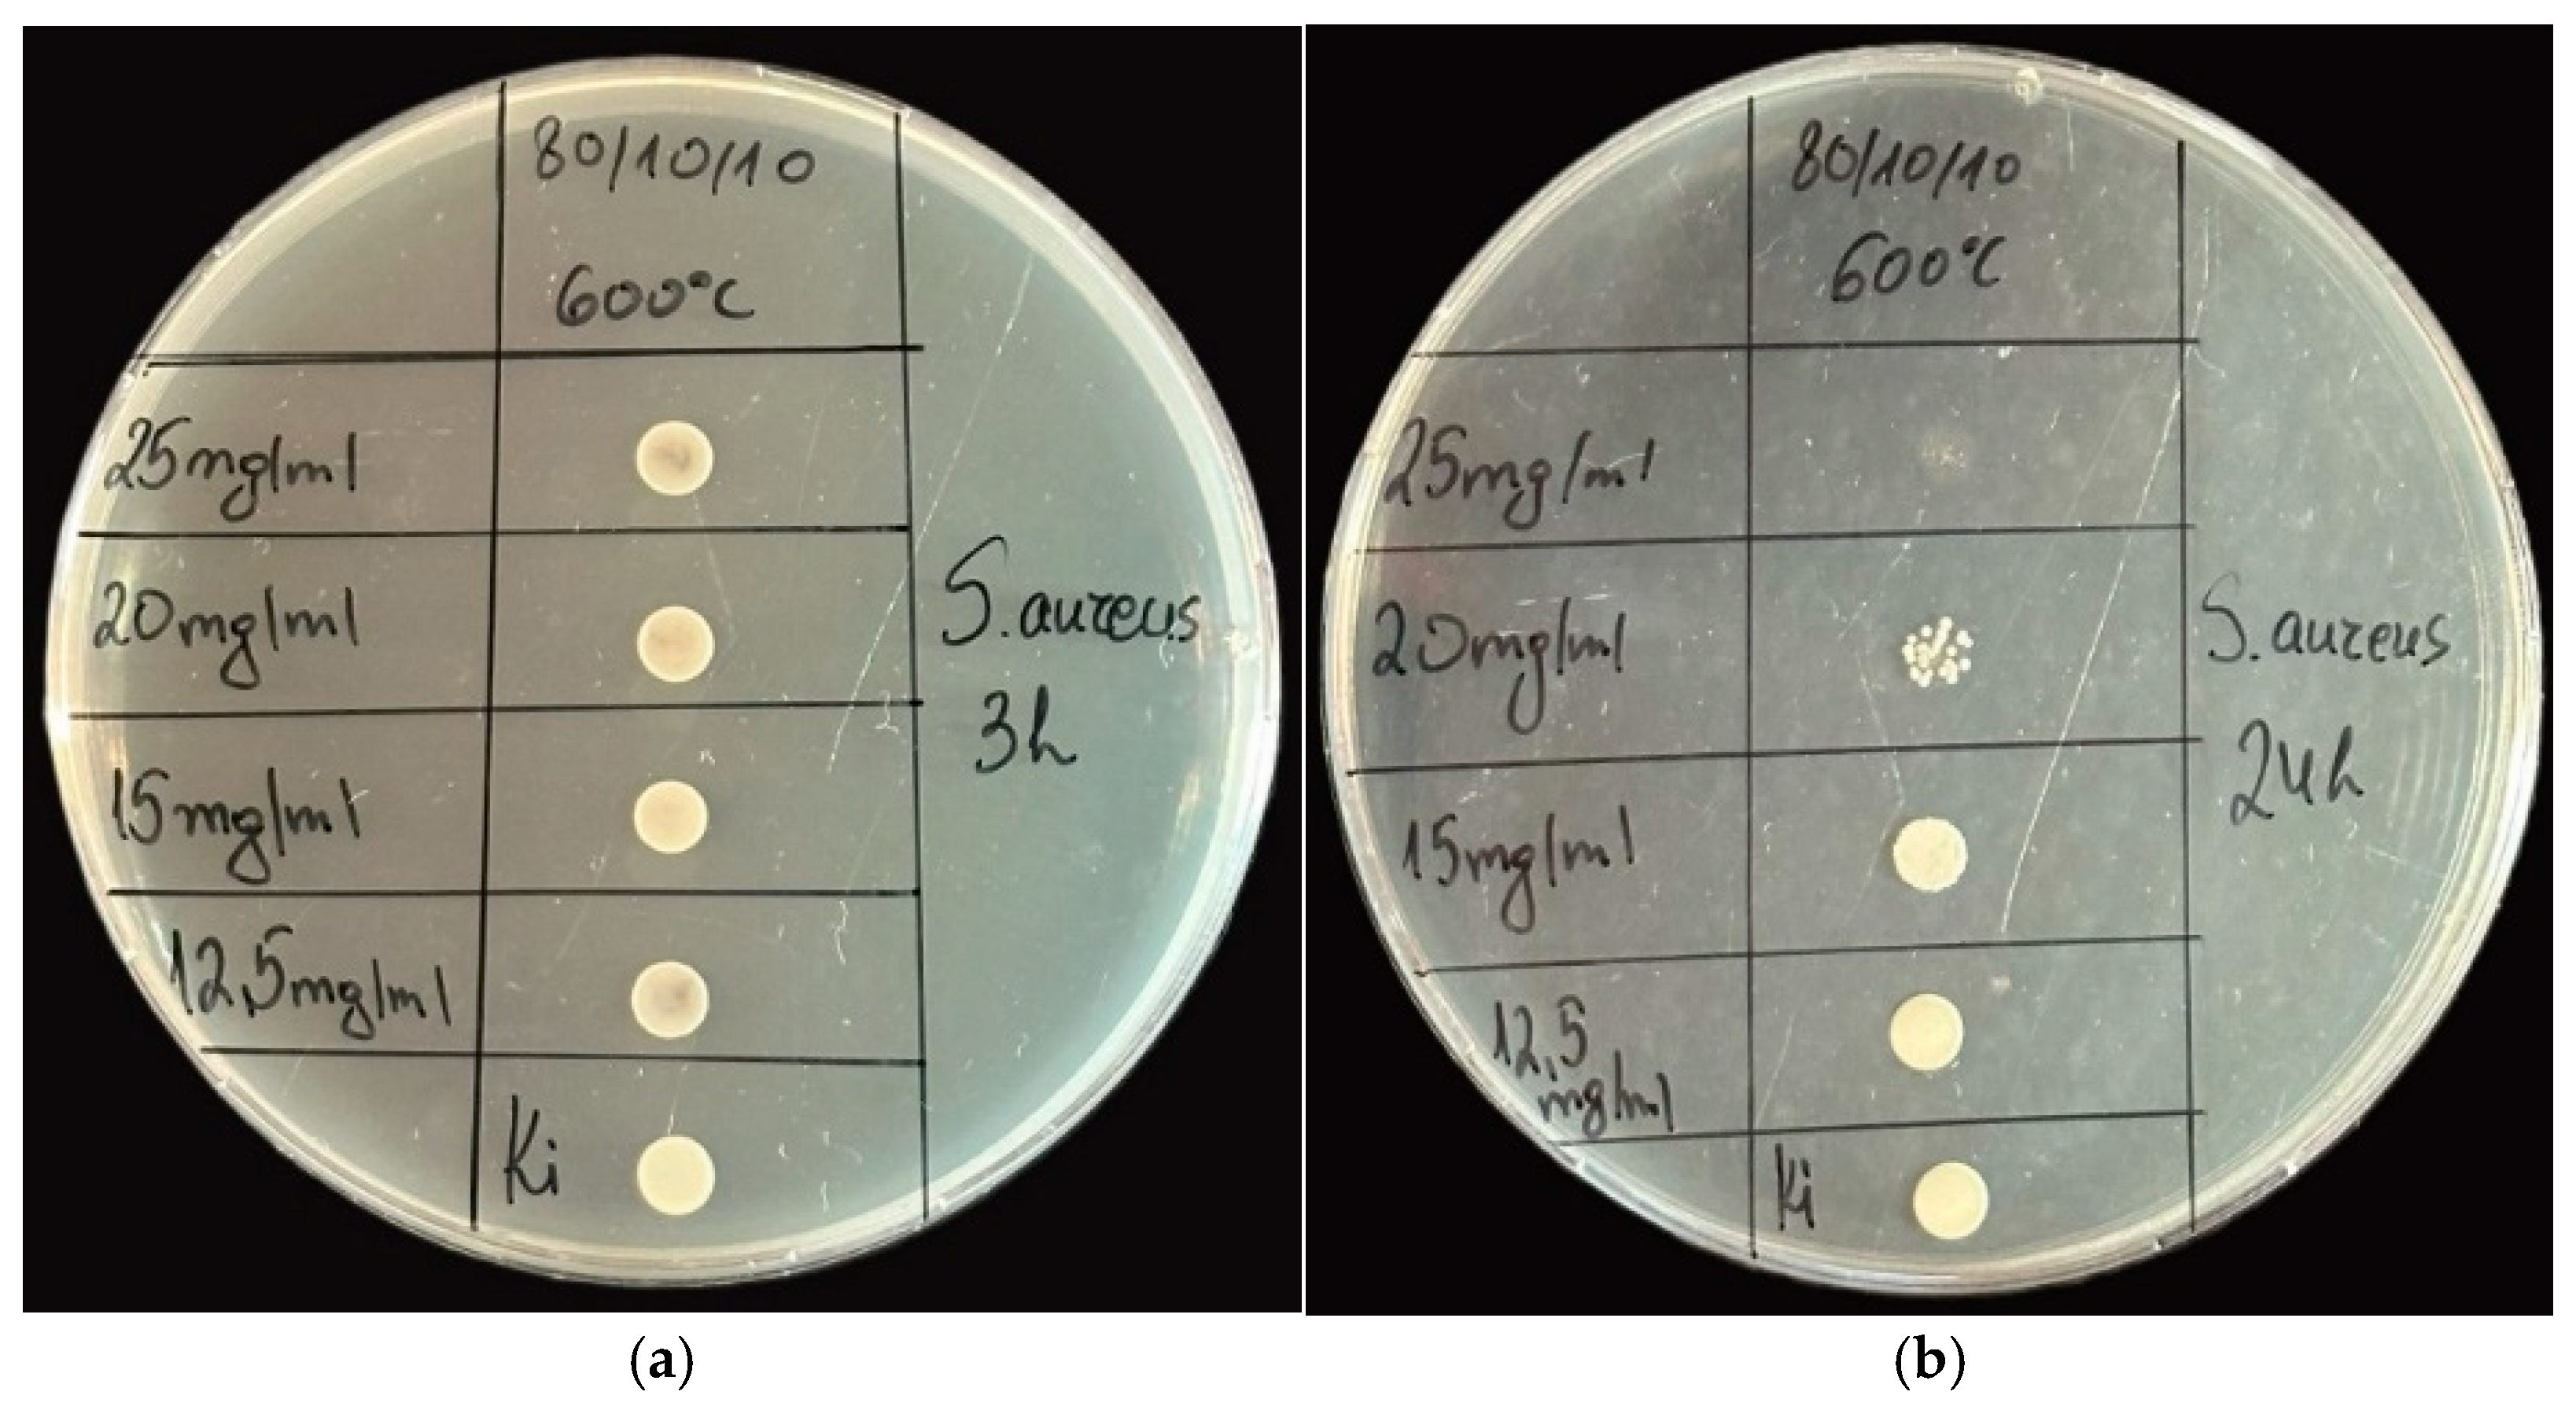
Gels 11 00716 g007 Gels 11 00716 g007
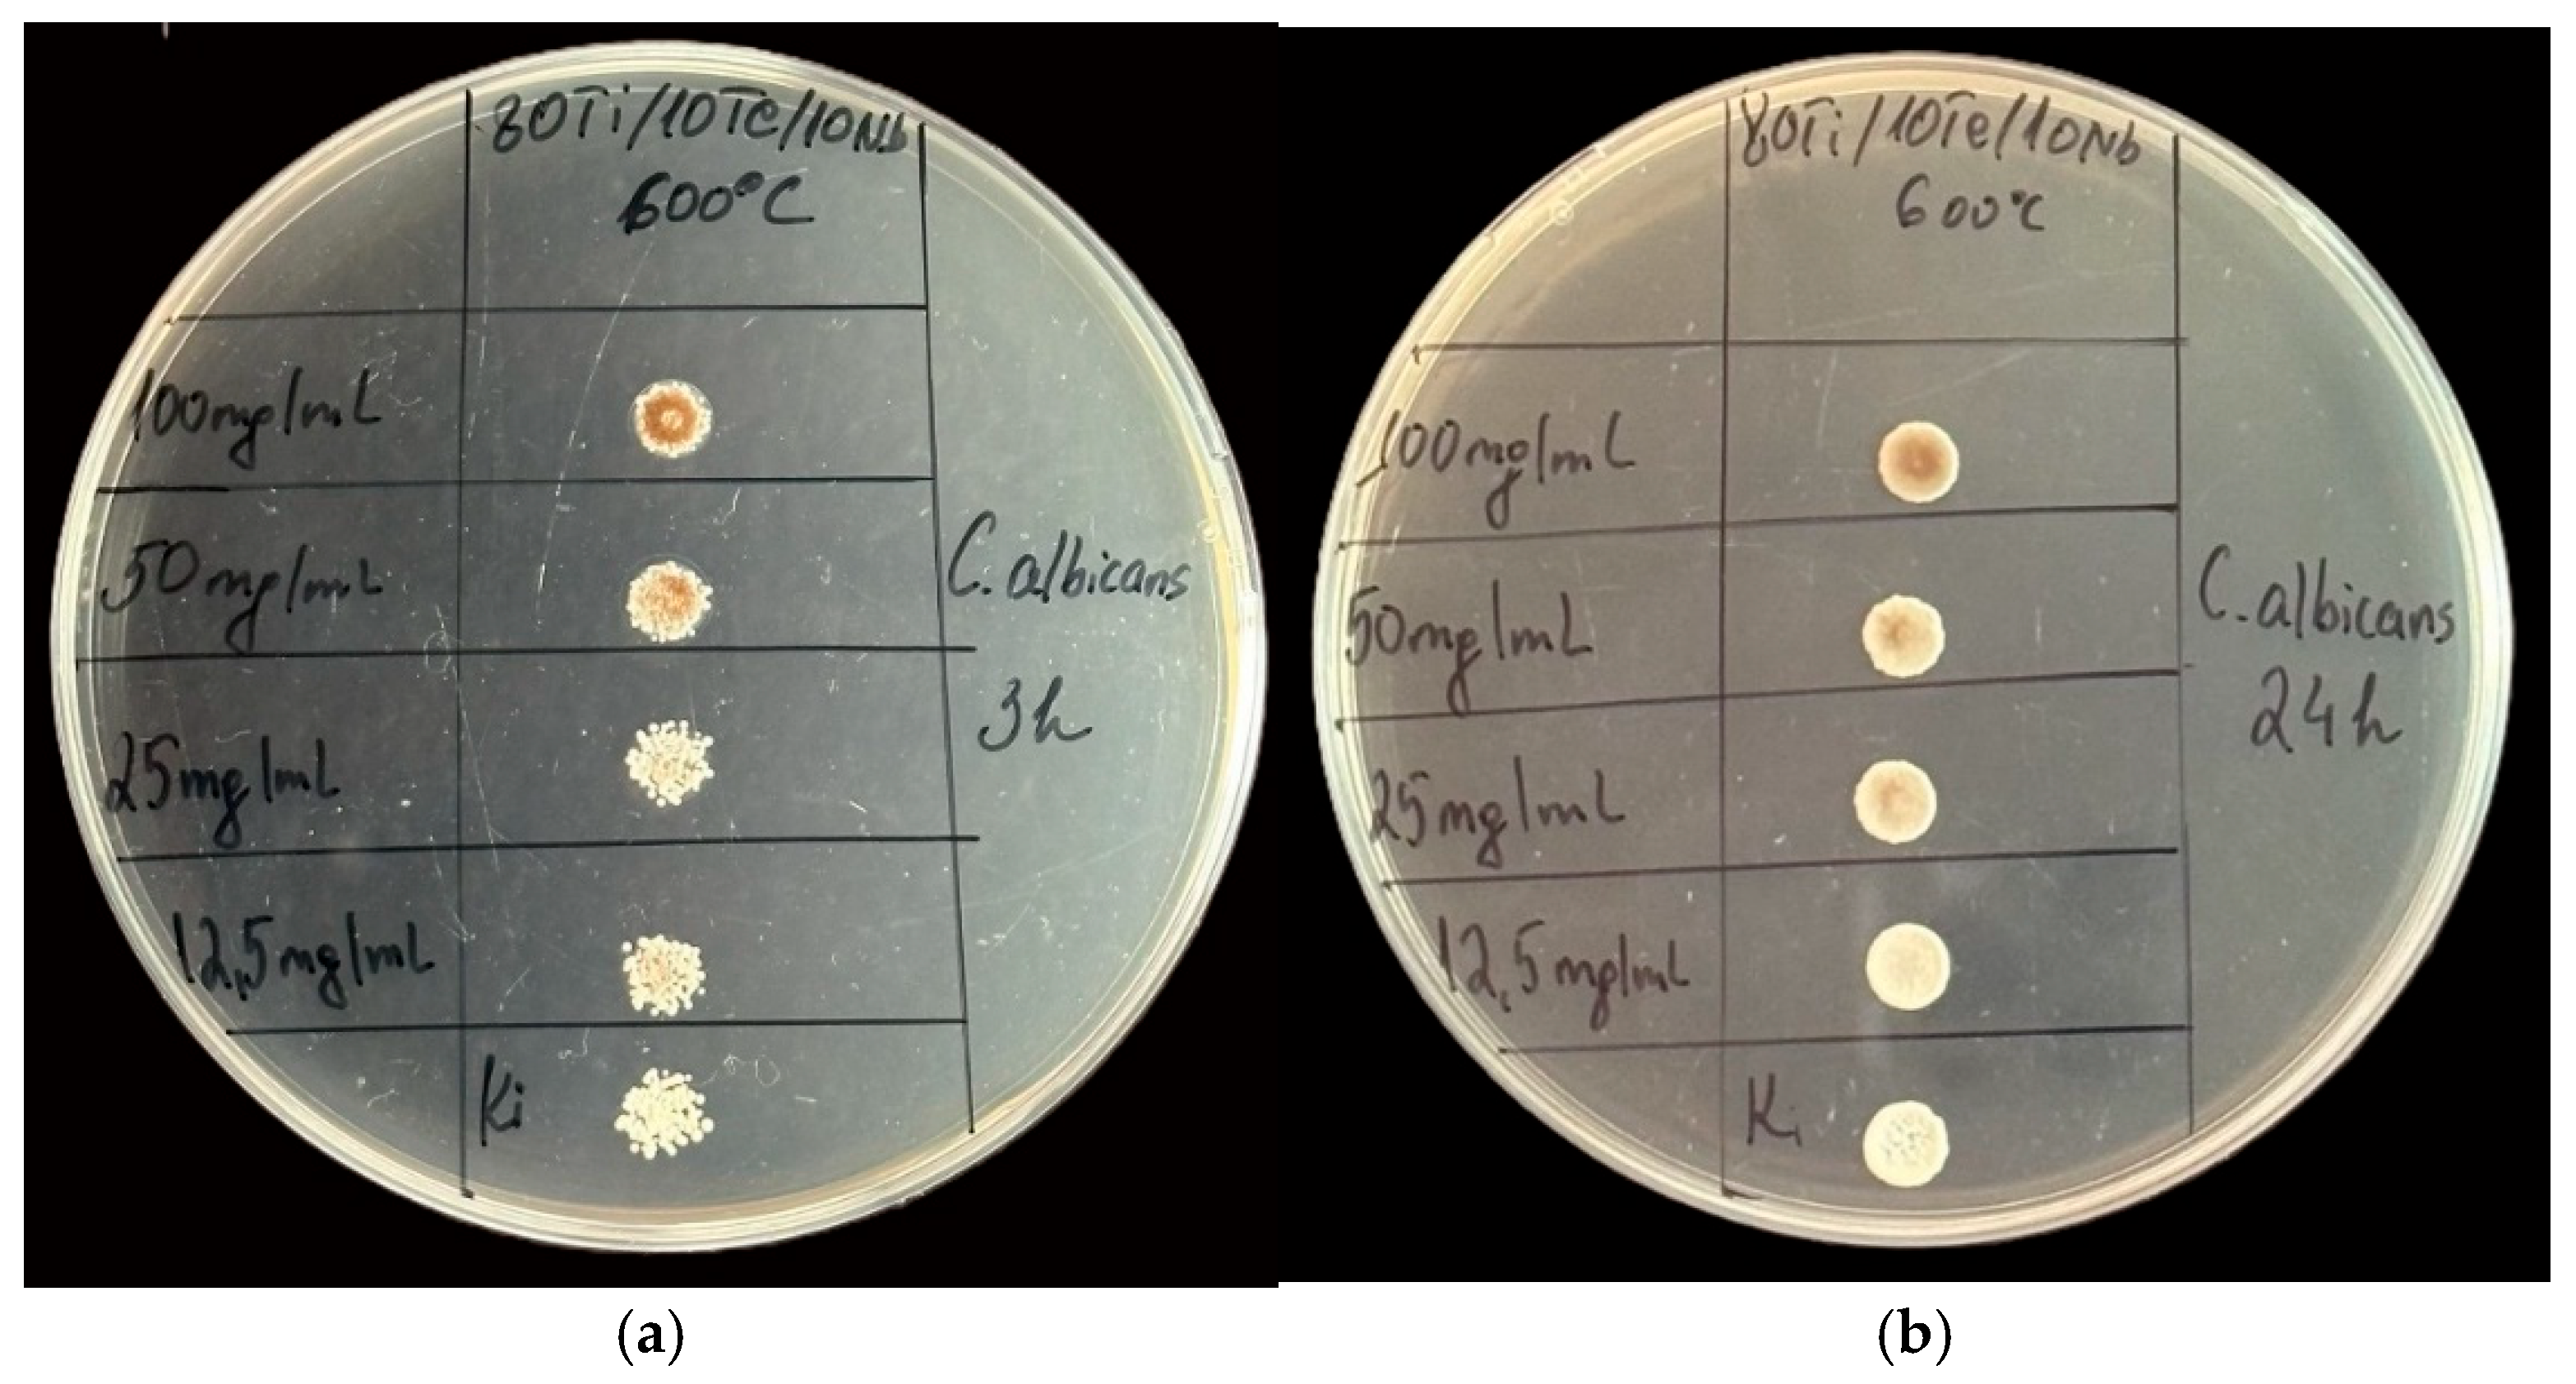
Gels 11 00716 g011 Gels 11 00716 g011

The Antimicrobial Effect and ROS Redox Activity of Nb2O5-Containing Powders Obtained by the Sol–Gel Method
Abstract
1. Introduction
2. Results and Discussion
2.1. XRD and SEM-EDX Investigations of the Powders
Electron Microscopy and EDX Analysis
2.2. IR and UV-Vis Spectroscopy Results
2.3. Antimicrobial Property Results
2.4. Chemiluminescent ROS Redox Activity Tests
- It is possible that the sorption and stabilization of free radicals and ROS can take place on the surface of the nanocomposite—the oxides of titanium, tellurium, and niobium can probably act as surface traps for ROS, preventing their reactivity in the environment; their large mass, on the other hand, probably leads to rapid precipitation and hinders the reactions in an aqueous solution;
- It is possible that the catalytic degradation or transformation of ROS results in less reactive forms when the nanomaterial participates as a redox-active surface, especially at a higher pH 8.5, when the observed effects were most pronounced;
- Most likely, the newly synthesized material has selective, extremely weak pro-oxidant activity towards H2O2; this activity was registered only in weak, basic media (pH 8.5).
3. Conclusions
4. Materials and Methods
4.1. Gels Preparation
4.2. Samples Characterization
4.3. Antimicrobial Activity Testing
4.4. Activated Chemiluminescence Assay
- Fenton’s system: H2O2–FeSO4-generating hydroxyl (.OH) and hydroperoxyl (.OOH) radicals;
- System containing hydrogen peroxide (H2O2);
- (NAD.H–PhMS (phenazine methosulfate)) system generating superoxide radicals (O2−.);
- All experimental data were statistically processed by MSOffice Pro 2021 and Origin Pro 8; the significant effects were calculated as quantum yields, which are integral values describing the total light, emitted from the reaction;
- Fenton’s system: 0.2 mol sodium hydrogen phosphate buffer with the chosen pH, Fenton’s reagent (FeSO4 (5 × 10−4 mol)—H2O2 (1.5%)), and lucigenin (10−4 mol); the interaction follows the scheme below, producing various ROS:
- (1)
- Fe2+ + H2O2 → Fe3+ + .OH + −OH
- (2)
- Fe3+ + H2O2 → Fe2+ + ·OOH + H+
- System containing hydrogen peroxide (H2O2): 0.2 mol sodium hydrogen phosphate buffer with the chosen pH, H2O2 (1.5%), and lucigenin (10−4 mol); in this chemical model system, hydrogen peroxide reacts as an oxidant and a ROS.
- NAD.H–PhMS: 0.2 mol sodium hydrogen phosphate buffer with the chosen pH, NAD.H (10−4 mol), phenazine methosulfate (10−6 mol), and lucigenin (10−4 mol); the interaction is following the scheme below, producing superoxide radicals:
- (1)
- PhMS + NAD.H + H+→ PhMS.H2 + NAD+
- (2)
- PhMS.H2 + PhMS → 2 PhMS.H.
- (3)
- PhMS.H. + O2 → PhMS + O2−. + H+
Supplementary Materials
Author Contributions
Funding
Institutional Review Board Statement
Informed Consent Statement
Data Availability Statement
Acknowledgments
Conflicts of Interest
References
- Serov, D.A.; Gritsaeva, A.V.; Yanbaev, F.M.; Simakin, A.V.; Gudkov, S.V. Review of Antimicrobial Properties of Titanium Dioxide Nanoparticles. Int. J. Mol. Sci. 2024, 25, 10519. [Google Scholar] [CrossRef]
- Ramirez, M.S.; Tolmasky, M.E. Aminoglycoside modifying enzymes. Drug Resist. Updat. 2010, 13, 151–171. [Google Scholar] [CrossRef] [PubMed]
- Annunziato, G. Strategies to overcome antimicrobial resistance (AMR) making use of non-essential target inhibitors: A review. Int. J. Mol. Sci. 2019, 20, 5844. [Google Scholar] [CrossRef]
- Prestinaci, F.; Pezzotti, P.; Pantosti, A. Antimicrobial resistance: A global multifaceted phenomenon. Pathog. Glob. Health 2015, 109, 309–318. [Google Scholar] [CrossRef]
- Moo, C.-L.; Yang, S.-K.; Yusoff, K.; Ajat, M.; Thomas, W.; Abushelaibi, A.; Lim, S.-H.-E.; Lai, K.-S. Mechanisms of Antimicrobial Resistance (AMR) and Alternative Approaches to Overcome AMR. Curr. Drug Discov. Technol. 2019, 17, 430–447. [Google Scholar] [CrossRef]
- Franco, D.; Calabrese, G.; Guglielmino, S.P.P.; Conoci, S. Metal-Based Nanoparticles: Antibacterial Mechanisms and Biomedical Application. Microorganisms 2022, 10, 1778. [Google Scholar] [CrossRef]
- Kim, J.S.; Kuk, E.; Yu, K.N.; Kim, J.-H.; Park, S.J.; Lee, H.J.; Kim, S.H.; Park, Y.K.; Park, Y.H.; Hwang, C.-Y.; et al. Antimicrobial effects of silver nanoparticles. Nanomed. Nanotechnol. Biol. Med. 2007, 3, 95–101. [Google Scholar] [CrossRef]
- Ranjan, S.; Ramalingam, C. Titanium dioxide nanoparticles induce bacterial membrane rupture by reactive oxygen species generation. Environ. Chem. Lett. 2016, 14, 487–494. [Google Scholar] [CrossRef]
- Ren, E.; Zhang, C.; Li, D.; Pang, X.; Liu, G. Leveraging metal oxide nanoparticles for bacteria tracing and eradicating. View 2020, 1, e24. [Google Scholar] [CrossRef]
- Wigginton, N.S.; de Titta, A.; Piccapietra, F.; Dobias, J.; Nesatyy, V.J.; Suter, M.J.F.; Bernier-Latmani, R. Binding of silver nanoparticles to bacterial proteins depends on surface modifications and inhibits enzymatic activity. Environ. Sci. Technol. 2010, 44, 2163–2168. [Google Scholar] [CrossRef]
- Wang, L.; He, H.; Yu, Y.; Sun, L.; Liu, S.; Zhang, C.; He, L. Morphology-dependent bactericidal activities of Ag/CeO2 catalysts against Escherichia coli. J. Inorg. Biochem. 2014, 135, 45–53. [Google Scholar] [CrossRef]
- Allafchian, A.; Hosseini, S.S. Antibacterial magnetic nanoparticles for therapeutics: A review. IET Nanobiotechnol. 2019, 13, 786–799. [Google Scholar] [CrossRef]
- Slavin, Y.N.; Asnis, J.; Häfeli, U.O.; Bach, H. Metal nanoparticles: Understanding the mechanisms behind antibacterial activity. J. Nanobiotechnol. 2017, 15, 65. [Google Scholar] [CrossRef]
- Cui, Y.; Zhao, Y.; Tian, Y.; Zhang, W.; Lü, X.; Jiang, X. The molecular mechanism of action of bactericidal gold nanoparticles on Escherichia coli. Biomaterials 2012, 33, 2327–2333. [Google Scholar] [CrossRef]
- Penesyan, A.; Paulsen, I.T.; Kjelleberg, S.; Gillings, M.R. Three faces of biofilms: A microbial lifestyle, a nascent multicellular organism, and an incubator for diversity. NPJ Biofilms Microbiomes 2021, 7, 80. [Google Scholar] [CrossRef] [PubMed]
- Mishra, A.; Pradhan, D.; Halder, J.; Biswasroy, P.; Rai, V.K.; Dubey, D.; Kar, B.; Ghosh, G.; Rath, G. Metal nanoparticles against multi-drug-resistance bacteria. J. Inorg. Biochem. 2022, 237, 111938. [Google Scholar] [CrossRef]
- Shabatina, T.I.; Vernaya, O.I.; Melnikov, M.Y. Hybrid Nanosystems of Antibiotics with Metal Nanoparticles—Novel Antibacterial Agents. Molecules 2023, 28, 1603. [Google Scholar] [CrossRef]
- Morena, A.G.; Bassegoda, A.; Hoyo, J.; Tzanov, T. Hybrid Tellurium-Lignin Nanoparticles with Enhanced Antibacterial Properties. ACS Appl. Mater. Interfaces 2021, 13, 14885–14893. [Google Scholar] [CrossRef] [PubMed]
- Ren, J.; Da, J.; Wu, W.; Zheng, C.; Hu, N. Niobium carbide–mediated photothermal therapy for infected wound treatment. Front. Bioeng. Biotechnol. 2022, 10, 934981. [Google Scholar] [CrossRef]
- Godoy-Gallardo, M.; Eckhard, U.; Delgado, L.M.; de Roo Puente, Y.J.D.; Hoyos-Nogués, M.; Gil, F.J.; Perez, R.A. Antibacterial approaches in tissue engineering using metal ions and nanoparticles: From mechanisms to applications. Bioact. Mater. 2021, 6, 4470–4490. [Google Scholar] [CrossRef] [PubMed]
- Kadiyala, U.; Kotov, N.A.; Vanepps, J.S. HHS Public Access. Curr. Top. Med. Chem. 2019, 24, 896–903. [Google Scholar]
- Huh, A.J.; Kwon, Y.J. “Nanoantibiotics”: A new paradigm for treating infectious diseases using nanomaterials in the antibiotics resistant era. J. Control. Release 2011, 156, 128–145. [Google Scholar] [CrossRef] [PubMed]
- Preda, S.; Pandele-Cușu, J.; Petrescu, S.V.; Ciobanu, E.M.; Petcu, G.; Culiță, D.C.; Apostol, N.G.; Costescu, R.M.; Raut, I.; Constantin, M.; et al. Photocatalytic and Antibacterial Properties of Doped TiO2 Nanopowders Synthesized by Sol−Gel Method. Gels 2022, 8, 673. [Google Scholar] [CrossRef]
- Priyanka, K.P.; Sukirtha, T.H.; Balakrishna, K.M.; Varghese, T. Microbicidal activity of TiO2 nanoparticles synthesised by sol-gel method. IET Nanobiotechnol. 2016, 10, 81–86. [Google Scholar] [CrossRef]
- Vávrová, S.; Struhárňanská, E.; Turňa, J.; Stuchlík, S. Tellurium: A rare element with influence on prokaryotic and eukaryotic biological systems. Int. J. Mol. Sci. 2021, 22, 5924. [Google Scholar] [CrossRef]
- Lohmeier-Vogel, E.M.; Ung, S.; Turner, R.J. In vivo 31P nuclear magnetic resonance investigation of tellurite toxicity in Escherichia coli. Appl. Environ. Microbiol. 2004, 70, 7342–7347. [Google Scholar] [CrossRef] [PubMed]
- Ao, B.; Jiang, H.; Cai, X.; Liu, D.; Tu, J.; Shi, X.; Wang, Y.; He, F.; Lv, J.; Li, J.; et al. Synthesis of Tellurium Nanoparticles Using Moringa oleifera Extract, and Their Antibacterial and Antibiofilm Effects against Bacterial Pathogens. Microorganisms 2024, 12, 1847. [Google Scholar] [CrossRef]
- Babaei, K.; Fattah-alhosseini, A.; Chaharmahali, R. A review on plasma electrolytic oxidation (PEO) of niobium: Mechanism, properties and applications. Surf. Interfaces 2020, 21, 100719. [Google Scholar] [CrossRef]
- Ge, Y.; Wang, Y.; Cui, Y.; Zou, Y.; Guo, L.; Ouyang, J.; Jia, D.; Zhou, Y. Growth of plasma electrolytic oxidation coatings on Nb and corresponding corrosion resistance. Appl. Surf. Sci. 2019, 491, 526–534. [Google Scholar] [CrossRef]
- Ramírez, G.; Rodil, S.E.; Arzate, H.; Muhl, S.; Olaya, J.J. Niobium based coatings for dental implants. Appl. Surf. Sci. 2011, 257, 2555–2559. [Google Scholar] [CrossRef]
- Bachvarova-Nedelcheva, A.; Iordanova, R.; Georgieva, N.; Nemska, V.; Foteva, T.; Stoyanova, A. Influence of Nb2O5 and B2O3 on the photocatalytic and antibacterial activity of sol-gel derived TiO2 nanopowders. J. Chem. Technol. Metall. 2024, 59, 335–342. [Google Scholar] [CrossRef]
- Souza, L.V.S.; Pavanello, L.; Picolo, M.Z.D.; Kury, M.; Matos, I.C.R.T.; Cogo-Müller, K.; Esteban Florez, F.L.; Cavalli, V. Mechanical and antibacterial properties of an experimental flowable composite containing Nb2O5 and NF_TiO2 nanoparticles. J. Mech. Behav. Biomed. Mater. 2023, 143, 105919. [Google Scholar] [CrossRef]
- Boruah, B.; Gupta, R.; Modak, J.M.; Madras, G. Enhanced photocatalysis and bacterial inhibition in Nb2O5: Via versatile doping with metals (Sr, Y, Zr, and Ag): A critical assessment. Nanoscale Adv. 2019, 1, 2748–2760. [Google Scholar] [CrossRef] [PubMed]
- Pavlova, E.L.; Ivanova, I.A.; Staneva, A.D.; Kostadinova, A.S.; Kichukova, D.G.; Yocheva, L.D. Prooxidant, antioxidant and biological activity of nanocomposites of reduced graphene oxide, silver, copper and their combinations. Chem. Pap. 2022, 76, 6789–6800. [Google Scholar] [CrossRef]
- Pavlova, E.L.; Nenova, E.P.; Yocheva, L.D.; Ivanova, I.A.; Georgiev, P.A. Antimicrobial and oxidative activities of different levels of silver-exchanged zeolites X and ZSM-5 and their ecotoxicity. Pharmaceuticals 2024, 17, 1586. [Google Scholar] [CrossRef]
- Uza, N.U.; Dastagir, G.; Shah, S.T.; Pavlova, E.; Jamal, A.; Seleiman, M.F.; Černý, J. Green synthesis, characterization and pharmaceutical applications of biocompatible zinc oxide nanoparticles using Heliotropium rariflorum stocks. Pharmaceuticals 2024, 17, 1457. [Google Scholar] [CrossRef]
- Bachvarova-Nedelcheva, A.; Iordanova, R.; Georgieva, N.; Nemska, V.; Stoyanova, A. Photocatalytic and antibacterial assessment of sol–gel derived TiO2/TeO2/ZnO powders. J. Chem. Technol. Metall. 2022, 57, 589–597. [Google Scholar]
- Da Silva, A.L.; Muche, D.N.F.; Dey, S.; Hotza, D.; Castro, R.H.R. Photocatalytic Nb2O5-doped TiO2 nanoparticles for glazed ceramic tiles. Ceram. Int. 2016, 42, 5113–5122. [Google Scholar] [CrossRef]
- De Paulo Ferreira, E.; Bessa, L.P.; Cardoso, V.L.; Reis, M.H.M. Influence of sintering temperature on the morphology of ceramic hollow fibers prepared from niobium pentoxide. Int. J. Appl. Ceram. Technol. 2018, 15, 781–790. [Google Scholar] [CrossRef]
- Ristić, M.; Popović, S.; Musić, S. Sol–gel synthesis and characterization of Nb2O5 powders. Mater. Lett. 2004, 58, 2658–2663. [Google Scholar] [CrossRef]
- Georgiev, R.; Georgieva, B.; Vasileva, M.; Ivanov, P.; Babeva, T. Optical properties of sol-gel Nb2O5 films with tunable porosity for sensing applications. Adv. Condens. Matter Phys. 2015, 2015, 403196. [Google Scholar] [CrossRef]
- da Fonseca, B.T.; D’Elia, E.; Siqueira Júnior, J.M.; de Oliveira, S.M.; dos Santos Castro, K.L.; Ribeiro, E.S. Study of the Characteristics and Properties of the SiO2/TiO2/Nb2O5 Material Obtained by the Sol–Gel Process. Sci. Rep. 2021, 11, 1106. [Google Scholar] [CrossRef]
- Dias, D.T.; Rodrigues, A.O.; Pires, P.B.; Semianko, B.C.; Fuziki, M.E.; Lenzi, G.G.; Sabino, S.R. Photoacoustic Spectroscopy of Titanium Dioxide, Niobium Pentoxide, Titanium: Niobium, and Ruthenium-Modified Oxides Synthesized Using Sol–Gel Methodology. Appl. Spectrosc. 2024, 78, 1028–1042. [Google Scholar] [CrossRef]
- Ücker, C.L.; Riemke, F.; Goetzke, V.; Moreira, M.L.; Raubach, C.W.; Longo, E.; Cava, S. Facile Preparation of Nb2O5/TiO2 Heterostructures for Photocatalytic Application. Chem. Phys. Impact 2022, 4, 100079. [Google Scholar] [CrossRef]
- Iordanova, R.; Bachvarova-Nedelcheva, A.; Gegova, R.; Dimitriev, Y. Sol–Gel Synthesis of Composite Powders in the TiO2–TeO2–SeO2 System. J. Sol-Gel Sci. Technol. 2016, 79, 12–28. [Google Scholar] [CrossRef]
- Ivanova, K.; Bachvarova-Nedelcheva, A.; Iordanova, R.; Stoyanova, A.; Petrova, P.; Yordanova, L.; Ivanova, I. Synthesis, Luminescent and Antibacterial Properties of Sol–Gel TiO2/TeO2/Nb2O5 Powders. Materials 2025, 18, 946. [Google Scholar] [CrossRef] [PubMed]
- Dubey, R.S.; Krishnamurthy, K.V.; Singh, S. Experimental Studies of TiO2 Nanoparticles Synthesized by Sol–Gel and Solvothermal Routes for DSSCs Application. Results Phys. 2019, 14, 102390. [Google Scholar] [CrossRef]
- Doeuff, S.; Henry, M.; Sanchez, C.; Livage, J. Hydrolysis of Titanium Alkoxides: Modification of the Molecular Precursor by Acetic Acid. J. Non-Cryst. Solids 1987, 89, 206–216. [Google Scholar] [CrossRef]
- Uzunova-Bujnova, M.; Dimitrov, D.; Radev, D.; Bojinova, A.; Todorovsky, D. Effect of the Mechanoactivation on the Structure, Sorption and Photocatalytic Properties of Titanium Dioxide. Mater. Chem. Phys. 2008, 110, 291–298. [Google Scholar] [CrossRef]
- Kabalci, I.; Gökçe, H. Investigation of Infrared and Raman Spectra of TeO2–Nb2O5–TiO2 Glasses. Acta Phys. Pol. A 2014, 125, 877–882. [Google Scholar] [CrossRef]
- Aleksandrov, L.; Milanova, M.; Yordanova, A.; Iordanova, R.; Nedyalkov, N.; Petrova, P.; Tagiara, N.S.; Palles, D.; Kamitsos, E.I. Synthesis, Structure and Luminescence Properties of Eu3+-Doped 50ZnO·40B2O3·5WO3·5Nb2O5 Glass. Phys. Chem. Glas. Eur. J. Glass Sci. Technol. B 2023, 64, 101–109. [Google Scholar]
- Yan, J.; Wu, G.; Guan, N.; Li, L. Nb2O5/TiO2 Heterojunctions: Synthesis Strategy and Photocatalytic Activity. Appl. Catal. B Environ. 2014, 152–153, 280–288. [Google Scholar] [CrossRef]
- Barlier, V.; Bounor-Legare, V.; Boiteux, G.; Davenas, J. Hydrolysis–condensation reactions of titanium alkoxides in thin films: A study of the steric hindrance effect by X-ray photoelectron spectroscopy. Appl. Surf. Sci. 2008, 254, 5408–5412. [Google Scholar] [CrossRef]
- Sedneva, T.A.; Lokshin, E.P.; Belikov, M.L.; Belyaevskii, A.T. TiO2- and Nb2O5-based photocatalytic composites. Inorg. Mater. 2013, 49, 382–389. [Google Scholar] [CrossRef]
- Yan, C.; Xue, D. Formation of Nb2O5 nanotube arrays through phase transformation. Adv. Mater. 2008, 20, 1055. [Google Scholar] [CrossRef]
- Orel, B.; Maček, M.; Grdadolnik, J.; Meden, A. In situ UV-Vis and ex situ IR spectroelectrochemical investigations of amorphous and crystalline electrochromic Nb2O5 films in charged/discharged states. J. Solid State Electrochem. 1998, 2, 221–236. [Google Scholar] [CrossRef]
- Mohite, N.; Shinde, M.; Kumar Gupta, A.; Waghadkar, Y.; Gosavi, S.W.; Mohite, K.C.; Chauhan, R.; Rane, S. Facile synthesis of hollow urchin-like Nb2O5 nanostructures and their performance in dye-sensitized solar cells. J. Solid State Electrochem. 2020, 24, 6346–6352. [Google Scholar] [CrossRef]
- Liu, B.; Zhao, X.; Zhao, Q.; He, X.; Feng, J. Effect of heat treatment on the UV–vis–NIR and PL spectra of TiO2 films. J. Electron Spectrosc. Relat. Phenom. 2005, 148, 158–163. [Google Scholar] [CrossRef]
- Nagaveni, K.; Hegde, M.S.; Ravishankar, N.; Subbanna, G.N.; Madras, G. Synthesis and structure of TiO2 anatase nanocrystals with high photocatalytic activity. Langmuir 2004, 20, 2900–2907. [Google Scholar] [CrossRef]
- Ngyen Vi, V.N.H.; Beydoun, D.; Amal, R. Photocatalytic degradation of pesticide using titanium dioxide supported on porous materials. J. Photochem. Photobiol. A Chem. 2005, 171, 113–120. [Google Scholar]
- Meng, Z.D.; Zhu, L.; Ullah, K.; Ye, S.; Oh, W.-C. Influence of graphene oxide on the photocatalytic activity of TiO2 for the degradation of methylene blue under visible light irradiation. Mater. Res. Bull. 2014, 56, 45–53. [Google Scholar] [CrossRef]
- Wang, C.; Xu, B.-Q.; Wang, X.; Zhao, J. Enhanced photocatalytic activity of carbon-modified titanium dioxide for decomposition of organics in aqueous solution. J. Solid State Chem. 2005, 178, 3500–3506. [Google Scholar] [CrossRef]
- Bachvarova-Nedelcheva, A.; Iordanova, R.; Stoyanova, A.; Georgieva, N.; Nemska, V.; Foteva, T. Effect of B2O3 on the structure, properties and antibacterial abilities of sol-gel-derived TiO2/TeO2/B2O3 powders. Materials 2023, 16, 6400. [Google Scholar] [CrossRef]
- Stoyanova, A.; Hitkova, H.; Bachvarova-Nedelcheva, A.; Iordanova, R.; Ivanova, N.; Sredkova, M. Synthesis and antibacterial activity of TiO2/ZnO nanocomposites prepared via nonhydrolytic route. J. Chem. Technol. Metall. 2013, 48, 154–161. [Google Scholar]
- Lecomte, A.; Bamiere, F.; Coste, S.; Thomas, P.; Champarnaud-Mesjard, J.C. Sol–gel processing of TeO2 thin films from citric acid-stabilised tellurium isopropoxide precursor. J. Eur. Ceram. Soc. 2007, 27, 1151–1158. [Google Scholar] [CrossRef]
- Weng, L.; Hodgson, S. Sol–gel processing of tellurite materials from tellurium ethoxide precursor. Mater. Sci. Eng. B 2001, 87, 77–82. [Google Scholar] [CrossRef]
- Bachvarova-Nedelcheva, A.; Iordanova, R.; Naydenov, A.; Stoyanova, A.; Georgieva, N.; Nemska, V.; Foteva, T. Sol–gel obtaining of TiO2/TeO2 nanopowders with biocidal and environmental applications. Catalysts 2023, 13, 257. [Google Scholar] [CrossRef]
- Jorgensen, J.H.; Ferraro, M.J. Antimicrobial susceptibility testing: A review of general principles and contemporary practices. Clin. Infect. Dis. 2009, 49, 1749–1755. [Google Scholar] [CrossRef]
- Yordanova, L.; Simeonova, L.; Metodiev, M.; Bachvarova-Nedelcheva, A.; Kostova, Y.; Atanasova-Vladimirova, S.; Nenova, E.; Ivanova, I.; Yocheva, L.; Pavlova, E. Antimicrobial, Oxidant, Cytotoxic, and Eco-Safety Properties of Sol–Gel-Prepared Silica–Copper Nanocomposite Materials. Pharmaceuticals 2025, 18, 976. [Google Scholar] [CrossRef]

| Samples | Gels | Heat-Treated Samples (600 °C) | ||
|---|---|---|---|---|
| Cut-Off (nm) | Eg (eV) | Cut-Off (nm) | Eg (eV) | |
| TiO2 from Ti(IV) butoxide | 389.71 | 3.18 | 412.5 | 3.01 |
| 80TiO2/10TeO2/10Nb2O5 | 363.2 | 3.41 | 454.2 | 2.73 |
Disclaimer/Publisher’s Note: The statements, opinions and data contained in all publications are solely those of the individual author(s) and contributor(s) and not of MDPI and/or the editor(s). MDPI and/or the editor(s) disclaim responsibility for any injury to people or property resulting from any ideas, methods, instructions or products referred to in the content. |
© 2025 by the authors. Licensee MDPI, Basel, Switzerland. This article is an open access article distributed under the terms and conditions of the Creative Commons Attribution (CC BY) license (https://creativecommons.org/licenses/by/4.0/).
Share and Cite
Ivanova, K.; Pavlova, E.; Ivanova, I.; Bachvarova-Nedelcheva, A. The Antimicrobial Effect and ROS Redox Activity of Nb2O5-Containing Powders Obtained by the Sol–Gel Method. Gels 2025, 11, 716. https://doi.org/10.3390/gels11090716
Ivanova K, Pavlova E, Ivanova I, Bachvarova-Nedelcheva A. The Antimicrobial Effect and ROS Redox Activity of Nb2O5-Containing Powders Obtained by the Sol–Gel Method. Gels. 2025; 11(9):716. https://doi.org/10.3390/gels11090716
Chicago/Turabian StyleIvanova, Kalina, Elitsa Pavlova, Iliana Ivanova, and Albena Bachvarova-Nedelcheva. 2025. "The Antimicrobial Effect and ROS Redox Activity of Nb2O5-Containing Powders Obtained by the Sol–Gel Method" Gels 11, no. 9: 716. https://doi.org/10.3390/gels11090716
APA StyleIvanova, K., Pavlova, E., Ivanova, I., & Bachvarova-Nedelcheva, A. (2025). The Antimicrobial Effect and ROS Redox Activity of Nb2O5-Containing Powders Obtained by the Sol–Gel Method. Gels, 11(9), 716. https://doi.org/10.3390/gels11090716

